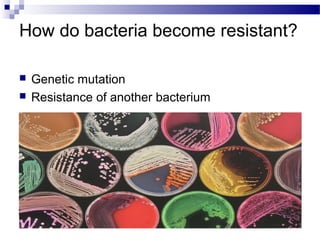
How do bacteria become resistant?
 Genetic mutation
 Resistance of another bacterium

Embed presentation
Download to read offline








Antibiotic resistance occurs when bacteria evolve and adapt to antibiotics, making the drugs less effective at killing the bacteria. Bacteria can become resistant through genetic mutation or by acquiring resistance genes from other bacteria via processes like conjugation. As antibiotic resistance spreads, it leads to increased treatment failure rates, mortality, and healthcare costs. To prevent further development and spread of resistance, patients should only take antibiotics as prescribed by doctors and not expect them for viral infections like colds.